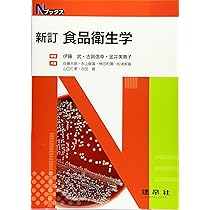

マイストア
変更
お店で受け取る
(送料無料)
配送する
納期目安:
06月12日頃のお届け予定です。
決済方法が、クレジット、代金引換の場合に限ります。その他の決済方法の場合はこちらをご確認ください。
※土・日・祝日の注文の場合や在庫状況によって、商品のお届けにお時間をいただく場合がございます。
福袋セール 612kU2Q1OiL._AC_UF350, 健康+医学の詳細情報
612kU2Q1OiL._AC_UF350,。Amazon | 健美舎 真潤 プラセンタ neoドリンク 500mL (4) | 楽。Amazon.co.jp: チンギス紀 三 虹暈 (集英社文庫) : 北方 謙三: 本。
商品説明
著者:光琳
楽天市場】ヒアルロン酸 サプリ 50倍濃縮 プラセンタ 10,000mg
出版社:光琳
日本再生医療学会 テキストブック 再生医療〜創る、行う、支える〜 第1版 2019 031M3D
サイズ:ペーパーバック
エンタプライズ 咬合整体療法の基礎 顎移動によるセルフコントロール療法≪JSC療法≫ 1996 山田唯勝 023M6D
ISBN-10:4771291071
カレント内科 4/金原出版/鳥飼勝隆(単行本)
ISBN-13:9784771291072
医育機関名簿 1999-2000/羊土社/羊土社(単行本)
【中古】 やさしい解剖生理学/金芳堂/駒田格知
■お値段の交渉、お取り置き、また購入前の商品状態の問い合わせについてはお答えできませんので、あらかじめご了承ください。
ER心電図の超速診断
心筋保護法標準テキストブック
■通常24時間以内に出荷可能です。あらかじめご了承ください。
脳脊髄誘発電位/朝倉書店/中西孝雄(大型本)
※商品のサイズなどによっては、日本郵便ゆうパック、ヤマト運輸宅急便での出荷となります。
産業医ハンドブック/南江堂/杉本寛治(単行本)
Urologic surgeryシリ-ズ No7/メジカルビュ-社/並木幹夫(大型本)
■中古品ではございますが、良好なコンディションです。
耳鼻咽喉科Q&A 2/金原出版/設楽哲也(単行本)
胃拡大内視鏡 /日本メディカルセンタ-/八尾建史(単行本)
■クリーニング済み。また、商品画像に「帯」が付いているものがありますが、中古品のため、実際の商品には付いていない場合がございます。
【中古】 よくわかる脳卒中の話/海鳥社/大里理恵
書き込みや線引きはありません。
脳神経外科わたしの手術記録 挑戦し続ける脳神経外科チ-ムの軌跡 2/メディカ出版/松本健五(単行本)
ページやカバーに欠品はありません。
【中古】 一歩、一歩 小児神経科医のあゆみ/慶應義塾大学出版会/黒川徹
・可:
Annual review血液 2006/中外医学社/高久史麿(単行本)
文章が問題なく読める状態の商品です。
表解注射薬の配合変化 混注時の留意点 改訂8版/じほう/宮本剛典(単行本)
商品の痛みがあったり、付属品がついていない場合があります。【中古】 鬱から晴れ晴れ気分! 明るく爽快になる気分転換法/ロングセラーズ/穂積登。
医薬品の開発 第7巻/広川書店/鈴木郁生(単行本)
製薬関係通知集 1999年版/じほう/薬事審査研究会(大型本)
■他にご注文頂いた商品がある場合でも、「同梱」は承っておりません。実践!「効果のあがる」スプリント治療の進め方 パラファンクションから睡眠時無呼吸症候群まで/インタ-アクション/今井俊広(ペーパーバック)。【中古】 おだやかで幸せな死を迎えるための23の方法 たくさんの「最期の瞬間」により添ってわかった/新人物往来社/堀エリカ。
リハビリテ-ション医学全書 3 第2版/医歯薬出版(単行本)
※繁忙期やセール等、ご注文数が多い日につきましては
【中古】 卵殻カルシウムのすごい効果 病気も老化も見事に防ぐ 2ケ月飲めば細胞が2年若返/ブックマン社/高橋愛子
発送まで48時間かかる場合があります。【中古】 尿の悩みを解決する本/教育書籍/木村明。【中古】 激しい変動期その時あなたの選択は?/文芸社/鷹崎長二郎。
循環器疾患の治療指針 第2版/丸善出版/国立循環器病センタ-(単行本)
ブレンナ-臨床腎臓病学/医学書院/バリ・M.ブレンナ-(単行本)
■日本郵便ゆうメールにて出荷いたします。整体DVD計5枚【只野拓也のPLT療法 治療とカラダの真実】手技DVD。【中古】 Q&A形式ストーマケア こんな時どうする/日総研出版。
組織学 1/広川書店/ウィリアム・ブル-ム(単行本)
耳鼻咽喉科診療プラクティス 5 /文光堂/池田勝久(単行本)
■ただいま、オリジナルカレンダーをプレゼントしております。【中古】 遠路 国際保健へ/保健文化社/遠藤昌一。咀嚼機能を支える臨床咬合論 欠損補綴とインプラントのために/医歯薬出版/河野正司(単行本(ソフトカバー))。
Annual Review消化器 2002/中外医学社/戸田剛太郎(単行本)
DVD>極上の癒し!タイ・マッサ-ジ /BABジャパン/大槻一博(単行本)
■万が一品質に不備が有った場合は、返金対応。さぁ、レーザー治療をはじめよう! 皮膚科・形成外科のための保険診療と美容皮膚 2021 /克誠堂出版/河野太郎(形成外科)(単行本)。【中古】 医療百論 2012/日本医療総合研究所/先見創意の会。
歯科医療総研 ゼロから始める町歯科医のための勤務医育成マニュアル 前/後編 未開封/未使用品 DVD2巻 渡部憲裕 032s3D
中毒 診療のポイント/メディカル葵出版/和田攻(単行本)
■帯の有無、状態など商品画像と実際の商品とは異なる場合がございます。神経放射線診断学入門/朝倉書店/西本詮(単行本)。【中古】 病まずに生きる死に方健康学 安らかな老いを生き抜くために/文化創作出版/水野肇(医事評論家)。
新生理科学大系 6/医学書院/星猛(単行本)
有茎性大網法 その機能・手技・臨床応用 /金芳堂/北野司久(単行本)
■商品状態の表記につきまして
ネズミ・害虫の衛生管理/フジ・テクノシステム/茂木幸夫(単行本)
・非常に良い:
新生理科学大系 第4巻/医学書院(単行本)
使用されてはいますが、
【中古】 運動不足病に克つ!スーパー元気術/ベースボール・マガジン社/石河利寛
非常にきれいな状態です。【中古】 自力で治す腰痛 / 坂戸孝志 監修。乳房MRI指南書 図解所見から考えるMRI診断/メジカルビュ-社/堀文子(医師)(単行本)。
臨床心エコ-図判読講座 第2巻/金原出版(単行本)
・良い:
眼科診療図譜 2 /金原出版/太根節直(単行本)
比較的綺麗な状態の商品です。【中古】 薬史こぼれ話/薬事日報社/杉山茂。江戸時代朝鮮薬材調査の研究/慶應義塾大学出版会/田代和生(単行本)。
【中古】 新版看護学全書 30 第3版/メヂカルフレンド社
文章を読むのに支障はありません。完全版 脳血管内治療学 病態・治療法の本質的理解と臨床・研究発展のために/メディカ出版/滝和郎(単行本)。サイトカインストーム症候群 メカニズムと治療/朝倉書店/クロン・ランディ(単行本)。
臨床神経内科学 第2版/南山堂/平山恵造(単行本)
マーカーやペンで書込があることがあります。手術後鎮痛のすべて /文光堂/川真田樹人(単行本)。【中古】 EBウイルス/診断と治療社/柳井秀雄。
口腔の感染症とアレルギ- 改訂版/一世出版/奥田克爾(単行本)
腰痛 第2版/医歯薬出版/イアン・マクナブ(単行本)
#もったいない本舗
Atlas now骨・関節疾患の画像診断 2/診断と治療社(単行本)
インプラント・シミュレ-ションの臨床 SIM/Plantの応用/クインテッセンス出版/水木信之(単行本)
書名カナ:ケンコウショクヒンロン
【中古】 新版看護学全書 11/メヂカルフレンド社
著者名:富田勉
耳鼻咽喉科診断治療大系 7 /講談社/野村恭也(単行本)
著者名カナ:トミタ,ツトム
臨床心エコ-図判読講座 第3巻/金原出版(単行本)
シリーズ名:光琳テクノブックス
成人矯正歯科アトラス /西村書店(新潟)/マヌエル・H.マ-クス(大型本)
シリーズ名カナ:コウリンテクノブックス
糖尿病動物 第2巻/医薬ジャ-ナル社/後藤由夫(単行本)
発行者:光琳
臨床のための筋病理 第2版/日本医事新報社/埜中征哉(単行本)
発行者カナ:コウリン
医学英訳活用辞典 /金芳堂/横井川泰弘(単行本)
ページ数:483p
ベッドサイドの画像診断/ヒュ-マン・ティワイ/片山仁(単行本)
サイズ:22
医療施設調査・病院報告 静態調査・動態調査 平成17年 下巻(都道府県編) /厚生労働統計協会/厚生労働省(単行本)
発売年月日:1995年06月30日
医療施設調査病院報告 静態調査動態調査 平成20年 下巻(都道府県編)/厚生労働統計協会/厚生労働省(単行本)
楽天市場】ヒアルロン酸 サプリ 50倍濃縮 プラセンタ 10,000mg
出版社:光琳
日本再生医療学会 テキストブック 再生医療〜創る、行う、支える〜 第1版 2019 031M3D
サイズ:ペーパーバック
エンタプライズ 咬合整体療法の基礎 顎移動によるセルフコントロール療法≪JSC療法≫ 1996 山田唯勝 023M6D
ISBN-10:4771291071
カレント内科 4/金原出版/鳥飼勝隆(単行本)
ISBN-13:9784771291072
医育機関名簿 1999-2000/羊土社/羊土社(単行本)
【中古】 やさしい解剖生理学/金芳堂/駒田格知
■お値段の交渉、お取り置き、また購入前の商品状態の問い合わせについてはお答えできませんので、あらかじめご了承ください。
ER心電図の超速診断
心筋保護法標準テキストブック
■通常24時間以内に出荷可能です。あらかじめご了承ください。
脳脊髄誘発電位/朝倉書店/中西孝雄(大型本)
※商品のサイズなどによっては、日本郵便ゆうパック、ヤマト運輸宅急便での出荷となります。
産業医ハンドブック/南江堂/杉本寛治(単行本)
Urologic surgeryシリ-ズ No7/メジカルビュ-社/並木幹夫(大型本)
■中古品ではございますが、良好なコンディションです。
耳鼻咽喉科Q&A 2/金原出版/設楽哲也(単行本)
胃拡大内視鏡 /日本メディカルセンタ-/八尾建史(単行本)
■クリーニング済み。また、商品画像に「帯」が付いているものがありますが、中古品のため、実際の商品には付いていない場合がございます。
【中古】 よくわかる脳卒中の話/海鳥社/大里理恵
書き込みや線引きはありません。
脳神経外科わたしの手術記録 挑戦し続ける脳神経外科チ-ムの軌跡 2/メディカ出版/松本健五(単行本)
ページやカバーに欠品はありません。
【中古】 一歩、一歩 小児神経科医のあゆみ/慶應義塾大学出版会/黒川徹
・可:
Annual review血液 2006/中外医学社/高久史麿(単行本)
文章が問題なく読める状態の商品です。
表解注射薬の配合変化 混注時の留意点 改訂8版/じほう/宮本剛典(単行本)
商品の痛みがあったり、付属品がついていない場合があります。【中古】 鬱から晴れ晴れ気分! 明るく爽快になる気分転換法/ロングセラーズ/穂積登。
医薬品の開発 第7巻/広川書店/鈴木郁生(単行本)
製薬関係通知集 1999年版/じほう/薬事審査研究会(大型本)
■他にご注文頂いた商品がある場合でも、「同梱」は承っておりません。実践!「効果のあがる」スプリント治療の進め方 パラファンクションから睡眠時無呼吸症候群まで/インタ-アクション/今井俊広(ペーパーバック)。【中古】 おだやかで幸せな死を迎えるための23の方法 たくさんの「最期の瞬間」により添ってわかった/新人物往来社/堀エリカ。
リハビリテ-ション医学全書 3 第2版/医歯薬出版(単行本)
※繁忙期やセール等、ご注文数が多い日につきましては
【中古】 卵殻カルシウムのすごい効果 病気も老化も見事に防ぐ 2ケ月飲めば細胞が2年若返/ブックマン社/高橋愛子
発送まで48時間かかる場合があります。【中古】 尿の悩みを解決する本/教育書籍/木村明。【中古】 激しい変動期その時あなたの選択は?/文芸社/鷹崎長二郎。
循環器疾患の治療指針 第2版/丸善出版/国立循環器病センタ-(単行本)
ブレンナ-臨床腎臓病学/医学書院/バリ・M.ブレンナ-(単行本)
■日本郵便ゆうメールにて出荷いたします。整体DVD計5枚【只野拓也のPLT療法 治療とカラダの真実】手技DVD。【中古】 Q&A形式ストーマケア こんな時どうする/日総研出版。
組織学 1/広川書店/ウィリアム・ブル-ム(単行本)
耳鼻咽喉科診療プラクティス 5 /文光堂/池田勝久(単行本)
■ただいま、オリジナルカレンダーをプレゼントしております。【中古】 遠路 国際保健へ/保健文化社/遠藤昌一。咀嚼機能を支える臨床咬合論 欠損補綴とインプラントのために/医歯薬出版/河野正司(単行本(ソフトカバー))。
Annual Review消化器 2002/中外医学社/戸田剛太郎(単行本)
DVD>極上の癒し!タイ・マッサ-ジ /BABジャパン/大槻一博(単行本)
■万が一品質に不備が有った場合は、返金対応。さぁ、レーザー治療をはじめよう! 皮膚科・形成外科のための保険診療と美容皮膚 2021 /克誠堂出版/河野太郎(形成外科)(単行本)。【中古】 医療百論 2012/日本医療総合研究所/先見創意の会。
歯科医療総研 ゼロから始める町歯科医のための勤務医育成マニュアル 前/後編 未開封/未使用品 DVD2巻 渡部憲裕 032s3D
中毒 診療のポイント/メディカル葵出版/和田攻(単行本)
■帯の有無、状態など商品画像と実際の商品とは異なる場合がございます。神経放射線診断学入門/朝倉書店/西本詮(単行本)。【中古】 病まずに生きる死に方健康学 安らかな老いを生き抜くために/文化創作出版/水野肇(医事評論家)。
新生理科学大系 6/医学書院/星猛(単行本)
有茎性大網法 その機能・手技・臨床応用 /金芳堂/北野司久(単行本)
■商品状態の表記につきまして
ネズミ・害虫の衛生管理/フジ・テクノシステム/茂木幸夫(単行本)
・非常に良い:
新生理科学大系 第4巻/医学書院(単行本)
使用されてはいますが、
【中古】 運動不足病に克つ!スーパー元気術/ベースボール・マガジン社/石河利寛
非常にきれいな状態です。【中古】 自力で治す腰痛 / 坂戸孝志 監修。乳房MRI指南書 図解所見から考えるMRI診断/メジカルビュ-社/堀文子(医師)(単行本)。
臨床心エコ-図判読講座 第2巻/金原出版(単行本)
・良い:
眼科診療図譜 2 /金原出版/太根節直(単行本)
比較的綺麗な状態の商品です。【中古】 薬史こぼれ話/薬事日報社/杉山茂。江戸時代朝鮮薬材調査の研究/慶應義塾大学出版会/田代和生(単行本)。
【中古】 新版看護学全書 30 第3版/メヂカルフレンド社
文章を読むのに支障はありません。完全版 脳血管内治療学 病態・治療法の本質的理解と臨床・研究発展のために/メディカ出版/滝和郎(単行本)。サイトカインストーム症候群 メカニズムと治療/朝倉書店/クロン・ランディ(単行本)。
臨床神経内科学 第2版/南山堂/平山恵造(単行本)
マーカーやペンで書込があることがあります。手術後鎮痛のすべて /文光堂/川真田樹人(単行本)。【中古】 EBウイルス/診断と治療社/柳井秀雄。
口腔の感染症とアレルギ- 改訂版/一世出版/奥田克爾(単行本)
腰痛 第2版/医歯薬出版/イアン・マクナブ(単行本)
#もったいない本舗
Atlas now骨・関節疾患の画像診断 2/診断と治療社(単行本)
インプラント・シミュレ-ションの臨床 SIM/Plantの応用/クインテッセンス出版/水木信之(単行本)
書名カナ:ケンコウショクヒンロン
【中古】 新版看護学全書 11/メヂカルフレンド社
著者名:富田勉
耳鼻咽喉科診断治療大系 7 /講談社/野村恭也(単行本)
著者名カナ:トミタ,ツトム
臨床心エコ-図判読講座 第3巻/金原出版(単行本)
シリーズ名:光琳テクノブックス
成人矯正歯科アトラス /西村書店(新潟)/マヌエル・H.マ-クス(大型本)
シリーズ名カナ:コウリンテクノブックス
糖尿病動物 第2巻/医薬ジャ-ナル社/後藤由夫(単行本)
発行者:光琳
臨床のための筋病理 第2版/日本医事新報社/埜中征哉(単行本)
発行者カナ:コウリン
医学英訳活用辞典 /金芳堂/横井川泰弘(単行本)
ページ数:483p
ベッドサイドの画像診断/ヒュ-マン・ティワイ/片山仁(単行本)
サイズ:22
医療施設調査・病院報告 静態調査・動態調査 平成17年 下巻(都道府県編) /厚生労働統計協会/厚生労働省(単行本)
発売年月日:1995年06月30日
医療施設調査病院報告 静態調査動態調査 平成20年 下巻(都道府県編)/厚生労働統計協会/厚生労働省(単行本)
商品情報
ベストセラーランキングです
近くの売り場の商品
カスタマーレビュー
オススメ度 4.1点
現在、3351件のレビューが投稿されています。